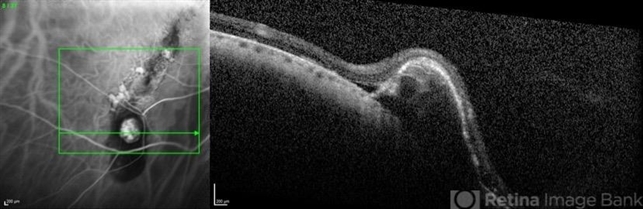
file

-
 By Pierre-Henry Gabrielle, MD
By Pierre-Henry Gabrielle, MD
DIJON university hospital - Uploaded on Jan 20, 2020.
- Last modified by Pierre-Henry Gabrielle, MD on Jan 21, 2020.
- Rating
- Appears in
- Tilted disc syndrome
- Condition/keywords
- tilted disc, atrophic pigment epithelium, polypoidal choroidal vasculopathy (PCV), optical coherence tomography (OCT), indocyanine green (ICG) angiography
- Photographer
- Pierre-Henry Gabrielle, Ophthalmology department, Dijon University Hospital, France.
- Imaging device
-
Optical coherence tomography system
Heidelberg spectralis - Description
- Coupled OCT B-scan and ICG angiography of an 81-year-old woman with a tilted disc syndrome complicated with RPE atrophy and polypoidal choroidal vasculopathy.

Initializing download.
Initializing download.








